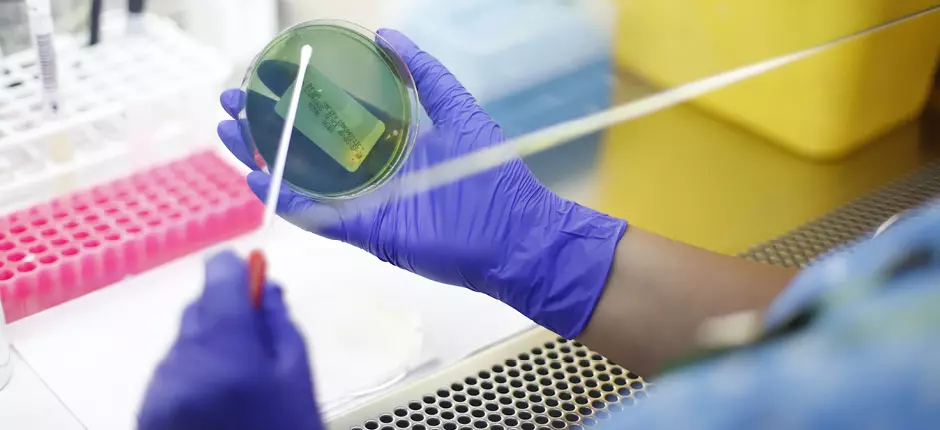
Innovación en tratamiento para mieloma múltiple

¡Nuestros primeros 10 años!
Agradecemos a los pacientes, sus familias y a todos los trabajadores por hacer posible que cumplamos una década.
Leer más

Asma: 7 consejos para cuidarse en otoño e invierno
La alta circulación de virus respiratorios en esta época puede gatillar episodios de crisis.
Leer más

Fenómeno Sephora Kids y la obsesión por el cuidado de la piel
La exposición a estándares de belleza a temprana edad puede provocar presiones y una autopercepción negativa.
Leer más

Cálculos biliares: principal factor de riesgo de cáncer de vesícula
Para detectar su presencia se aconseja realizarse una ecotomografía abdominal desde los 25 años.
Leer más

Cómo reconocer una reacción alérgica peligrosa y cuándo acudir a urgencias
Se debe acudir a un especialista ante alergias de todo tipo o problemas en el sistema inmunitario, para evitar llegar a situaciones graves que puedan poner en riesgo su vida.
Leer más

Climaterio y menopausia: cómo preparase para esta etapa y reconocer sus síntomas
Cambios en los ciclos menstruales, en el sueño y en el estado de ánimo son algunas señales del comienzo de esta fase.
Leer más

Factores que pueden afectar la voz y cómo cuidarla
Algunos consejos son hidratarse de manera correcta, no fumar y evitar gritar o hablar fuerte por periodos prolongados.
Leer más

14 consejos para prevenir contagios durante este invierno
Inmunización contra influenza, SARS-CoV-2 y virus respiratorio sincicial, además del autocuidado, son algunas de las medidas necesarias para evitar virus respiratorios.
Leer más

Uno de cada cinco de nuestros médicos son investigadores
La investigación permite estar a la vanguardia en medicina, contribuyendo a la entrega de una atención integral y de calidad a los pacientes.
Leer más

Cáncer colorrectal: se han duplicado los casos en menores de 50 años
Un test más sencillo y rápido que la colonoscopía puede detectar a tiempo lesiones que pudieran convertirse en un tumor.
Leer más

Trastorno Bipolar: cuando el estado de ánimo va de un extremo a otro
Ante la sospecha de sus síntomas, se debe consultar cuanto antes para hacer un diagnóstico precoz y comenzar el tratamiento.
Leer más

Nos adelantamos a la Ley de 40 horas
Para mejorar la calidad de vida de nuestros trabajadores, recortamos la jornada laboral a 39 horas semanales.
Leer más

Cuidados con el consumo de pescados y mariscos en Semana Santa
Este menú es una tradición en estas fechas, sin embargo, es importante recordar algunas medidas para disminuir la transmisión de enfermedades.
Leer más

Huevitos de chocolate: ¿hay una cantidad recomendable?
No están prohibidos, pero se debe moderar la ingesta por su alto contenido de azúcar y grasas saturadas.
Leer más

Extraordinarios avances en el tratamiento contra el cáncer
El Dr. Cristián Carvallo, oncólogo de nuestro Centro de Cáncer, explica las ventajas de esta alianza para la Clínica y los pacientes.
Leer más

Cuida la salud de tus trabajadores con nuestros Chequeos Preventivos Empresas
Leer más

Una nueva mirada al Síndrome de Down
La estimulación temprana y la inclusión son fundamentales para lograr el máximo nivel de funcionamiento y potenciar las habilidades.
Leer más

Tuberculosis: enfermedad bacteriana de gran prevalencia a nivel mundial
Es una patología que puede involucrar a varios órganos y la vacunación es la principal medida preventiva.
Leer más

Insuficiencia renal: cuando el riñón deja de limpiar el organismo
La detección y tratamiento temprano de esta enfermedad puede evitar que progrese a una etapa avanzada y, eventualmente, requerir diálisis o trasplante.
Leer más

Más de mil millones de personas en el mundo tienen obesidad
En niños y adolescentes las cifras se han cuadruplicado en 30 años.
Leer más
Innovación en tratamiento para mieloma múltiple
A través de un ensayo clínico, buscamos determinar la mejor forma de administración de una droga que mejora la calidad de vida de quienes padecen esta enfermedad oncológica.
Leer más

Juntos somos más innovación en cáncer
Nuestros equipos médicos y de enfermería están colaborando con sus pares del Mass General Hospital, 5° entre los mejores centros de salud del mundo y referente en tratamientos oncológicos.
Leer más

Beneficios del Omega 3 para el organismo
Este tipo de ácido graso saludable ha demostrado tener propiedades antiinflamatorias y antitrombóticas.
Leer más

Vuelta a la rutina: no olvidar que el Covid aún continúa
Leer más
